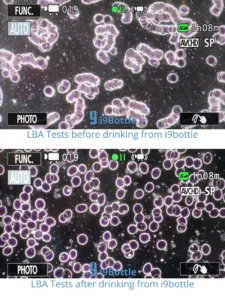
Bouteille I9 vitalisante, la structure du sang après utilisation

La bouteille I9 vitalisante vous permet de consommer une eau restructurée, informée, vivante tout au long de la journée.
Bouteille I9 vitalisante : votre eau structurée portable
La bouteille i9 vitalisante informée est énergisée grâce à la Technologie Poznik (TP), récompensée à l’international, qui redonne à l’eau sa vitalité naturelle. L’eau retrouve sa structure moléculaire originelle (son caractère « vivant »), devient plus douce et plus agréable à boire.
Fabriquée en verre de haute qualité, la bouteille i9 vitalisante constitue une alternative naturelle et durable aux contenants en plastique. Pour un usage quotidien confortable et sécurisé, le verre est protégé par des bandes en silicone qui améliorent la stabilité sur les surfaces glissantes, assurent une meilleure prise en main et offrent une protection supplémentaire contre les chocs accidentels.
Les bandes en silicone sont disponibles en couleurs tendance ou en couleurs des chakras, ouvrant la voie à une approche de bien-être par la thérapie par la couleur. La bouteille i9 vitalisante convient aussi bien aux boissons chaudes qu’aux boissons froides.
Produits i9, technologie et distinctions
Les produits i9 sont informés grâce à la Technologie Poznik (TP), dont l’effet positif sur la structure moléculaire de l’eau a été démontré à l’aide de codes informationnels spécifiques.
Chaque encodage est soumis à des protocoles de tests rigoureux, et chaque produit fini reçoit un certificat de qualité unique. Les bouteilles i9 vitalisantes informées bénéficient d’une garantie à vie sur l’encodage.
L’influence positive sur l’eau a été confirmée par des tests cytogénétiques ainsi que par le Berlin Institute of Electrophotonics. La Technologie Poznik (TP) repose sur 30 années de recherche et a été développée par une équipe d’inventeurs de renommée mondiale, totalisant plus de 90 récompenses et distinctions internationales pour leurs innovations et réalisations exceptionnelles.
Berlin Institute of Electrophotonics
Le Berlin Institute of Electrophotonics a mené des tests approfondis à l’aide d’une caméra GDV. Une caméra GDV (pour Gas Discharge Visualization, ou visualisation par décharge gazeuse) est un dispositif de mesure biophysique utilisé pour observer et analyser les émissions électrophotoniques produites par un organisme vivant lorsqu’il est soumis à un champ électromagnétique faible et pulsé (Effet Kirlian). Les résultats montrent que la consommation d’eau issue de la bouteille i9 vitalisante informée améliore le champ bio-énergétique humain de plus de 11 % et réduit les niveaux de stress d’environ 25 %, en comparaison avec la consommation d’eau provenant d’un verre classique.
Eau de boisson naturelle et “vivante”
Notre corps a besoin d’une eau « vivante », car seule une eau à l’état naturel traverse efficacement les membranes cellulaires et favorise le transport des nutriments essentiels.
Lorsque l’organisme ne reçoit pas d’eau naturellement énergisée, il puise dans ses propres réserves d’énergie pour la revitaliser, gaspillant ainsi une énergie précieuse normalement dédiée à l’auto-guérison, à l’homéostasie et au maintien de l’équilibre entre l’environnement interne et externe. Le système immunitaire s’en trouve alors affaibli et plus vulnérable face aux agressions.
Influence de la bouteille i9 vitalisante sur l’eau
- Influence la structure moléculaire et redonne à l’eau son état naturel,
- Encourage les capacités d’auto-nettoyage,
- Réduit le facteur génotoxique,
- Augmente le champ bio-énergétique,
- Rend l’eau plus douce et plus agréable à boire.
Boire suffisamment d’eau…et de bonne qualité
- Améliore l’hydratation du corps,
- Augmente les performances mentales et physiques,
- Améliore le niveau d’énergie et la vitalité,
- Renforce le système immunitaire et favorise la régénération cellulaire,
- Améliore la circulation sanguine,
- Ralentit le vieillissement,
- Favorise la détoxification de l’organisme.
La bouteille I9 vitalisante est le complément idéal d’un filtre vitalisant Amilo qui vous permet de purifier l’eau du robinet en éliminant le chlore, pesticides, PFAS, résidus de médicaments, microplastiques, métaux lourds…une fois microfiltrée, utilisez la bouteille I9 vitalisante pour maintenir l’effet de la vitalisation du filtre Amilo pendant plusieurs heures.
Ce que disent les clients
- Amélioration de la concentration et de la clarté mentale,
- Meilleure résistance face aux maladies,
- Réduction du stress et amélioration du sommeil,
- Soulagement des maux de tête et des migraines,
- Amélioration de la digestion.
IMPORTANT : Les témoignages clients n’ont pas été évalués par une autorité alimentaire et/ou de santé. Les produits i9 ne sont pas destinés à diagnostiquer, traiter ou prévenir une maladie. Les informations présentées ne remplacent en aucun cas l’avis d’un professionnel de santé qualifié. L’effet de la bouteille i9 sur l’eau dépend de la qualité de l’eau utilisée.
ENTRETIEN DE LA BOUTEILLE i9
Comme toute gourde, il est indispensable de nettoyer régulièrement sa bouteille i9 vitalisante pour éviter toute contamination indésirable. De même, nettoyer régulièrement le bouchon évitera l’apparition de moisissures (qui pourraient se développer en milieu humide).
Nettoyer sa bouteille i9 :
- ne pas passer en lave vaisselle afin d’éviter d’altérer ses propriétés.
- ne pas frotter l’étiquette avec des produits abrasifs.
- utiliser son produit habituel à l’intérieur de la bouteille (vinaigre, bicarbonate, billes d’acier, produits nettoyants, produits désinfectants, etc. …).
- utiliser un goupillon pour atteindre le fond de la bouteille.
- Nettoyer le bouchon et les anneaux (silicone alimentaire)
- retirer le bouchon et/ou les anneaux de la bouteille, faire bouillir de temps à autre et sécher soigneusement.
- laisser la bouteille i9 vitalisante ouverte le plus souvent possible.
- en cas de moisissures déjà installées, tenter une des recettes « traditionnelles » suivantes : brosser le bouchon – en vous aidant d’une brosse à dents – avec du savon noir OU du vinaigre blanc (ne pas laisser le bouchon tremper trop longtemps, le vinaigre « dissout » le silicone). Frotter avec un tissu imprégné d’alcool ménager OU d’ammoniaque OU encore de javel – se protéger les mains avec des gants.
- Rincer soigneusement avant toute utilisation.
Plus d’informations sur la bouteille I9 vitalisante ? consultez notre Foire Aux Questions dédiée.